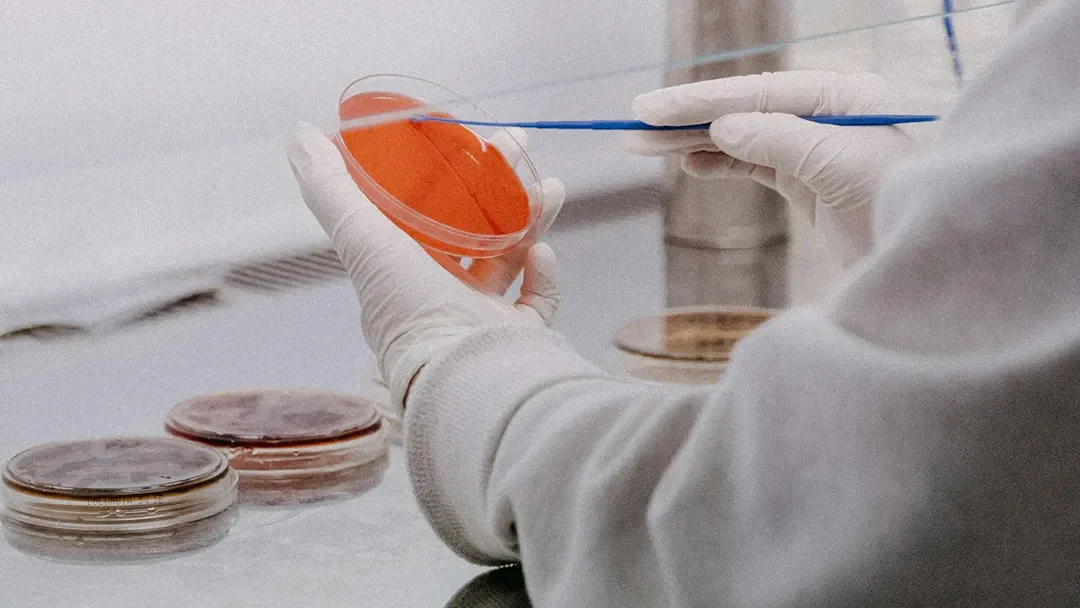
Retatrutide and Cancer Cell Research: What Preclinical Studies Are Showing

Not all fat is created equal. While subcutaneous fat — the kind you can pinch beneath the skin — is largely cosmetic, visceral fat is a different matter entirely. Stored deep in the abdominal cavity and wrapped around the organs, visceral adipose tissue (VAT) is...